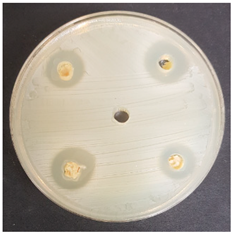
Beverages 06 00065 i008
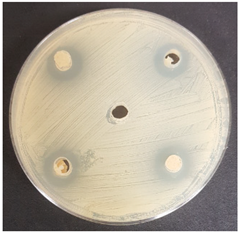
Beverages 06 00065 i009
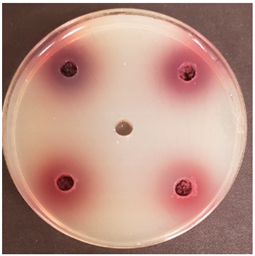
Beverages 06 00065 i011
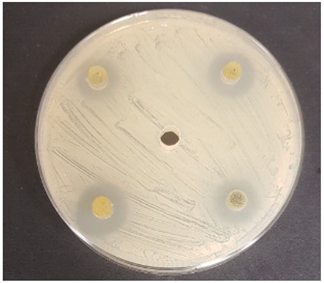
Beverages 06 00065 i034

Antimicrobial Potential of Beverages Preparation Based on Fermented Milk Permeate and Berries/Vegetables
Abstract
1. Introduction
2. Materials and Methods
2.1. Berries/Vegetables and Lactic Acid Bacteria Strains Used for the Development of Antimicrobial Combinations
2.2. Evaluation of the Berries/Vegetables and Fermented Milk Permeate Combination Antimicrobial Activity
2.3. Statistical Analysis
3. Results and Discussion
4. Conclusions
Supplementary Materials
Author Contributions
Funding
Acknowledgments
Conflicts of Interest
References
- Bartkiene, E.; Lele, V.; Sakiene, V.; Zavistanaviciute, P.; Ruzauskas, M.; Bernatoniene, J.; Jakstas, V.; Viskelis, P.; Zadeike, D.; Juodeikiene, G. Improvement of the antimicrobial activity of lactic acid bacteria in combination with berries/fruits and dairy industry by-products. J. Sci. Food Agric. 2019, 99, 3992–4002. [Google Scholar] [CrossRef] [PubMed]
- Belahsen, R.; Naciri, K.; El Ibrahimi, A. Food security and women’s roles in Moroccan Berber (Amazigh) society today. Matern. Child Nutr. 2018, 13. [Google Scholar] [CrossRef]
- Gu, J.; Liu, T.; Hou, J.; Pan, L.; Sadiq, F.A.; Yuan, L.; Yang, H.; He, G. Analysis of bacterial diversity and biogenic amines content during the fermentation processing of stinky tofu. Food Res. Int. 2018, 111, 689–698. [Google Scholar] [CrossRef] [PubMed]
- Zokaityte, E.; Cernauskas, D.; Klupsaite, D.; Lele, V.; Starkute, V.; Zavistanaviciute, P.; Ruzauskas, M.; Gruzauskas, R.; Juodeikiene, G.; Rocha, J.M.; et al. Bioconversion of Milk Permeate with Selected Lactic Acid Bacteria Strains and Apple By-Products into Beverages with Antimicrobial Properties and Enriched with Galactooligosaccharides. Microorganisms 2020, 8, 1182. [Google Scholar] [CrossRef]
- Gentili, R.; Fenu, G.; Citterio, C.; De Mattio, F.; Bachetta, G. Conservation genetics of two island endemic Ribes spp. (Grossulariaceae) of Sardinia: Survival or extinction? Plant Biol. 2015, 17, 1085–1094. [Google Scholar] [PubMed]
- Ramadan, M.F. Bioactive phytochemicals, nutritional value, and functional properties of cape gooseberry (Physalis peruviana): An overview. Food Res. Int. 2011, 44, 1830–1836. [Google Scholar]
- Ramadan, M.F. Physalis peruviana pomace suppresses highcholesterol diet-induced hypercholesterolemia in rats. Grasas Y Aceites 2012, 63, 411–422. [Google Scholar] [CrossRef]
- Rabie, M.A.; Soliman, A.Z.; Diaconeasa, Z.S.; Constantin, B. Effect of Pasteurization and Shelf Life on the Physicochemical Properties of Physalis (Physalis peruviana L.). J. Food Process. Preserv. 2015, 39, 1051–1060. [Google Scholar]
- Denev, P.N.; Kratchanov, C.G.; Číž, M.; Lojek, A.; Kratchanova, M.G. Bioavailability and Antioxidant Activity of Black Chokeberry (Aronia melanocarpa) Polyphenols: In vitro and in vivo Evidences and Possible Mechanisms of Action: A Review. Compr. Rev. Food Sci. Food Saf. 2012, 11, 471–489. [Google Scholar]
- Kulling, S.E.; Rawel, H.M. Chokeberry (Aronia melanocarpa)—A review on the characteristic components and potential health effects. Planta Med. 2008, 74, 1625–1634. [Google Scholar] [CrossRef]
- Valcheva-Kuzmanova, S.V.; Belcheva, A. Current knowledge of Aronia melanocarpa as a medicinal plant. Folia Med. 2006, 48, 11–17. [Google Scholar] [PubMed]
- Chrubasik, C.; Li, G.; Chrubasik, S. The clinical effectiveness of chokeberry: A systematic review. Phytother Res. 2010, 24, 1107–1114. [Google Scholar] [CrossRef] [PubMed]
- Howell, R.T.; Kern, M.L.; Lyubomirsky, S. Health benefits: Meta-analytically determining the impact of well-being on objective health outcomes. Health Psychol. Rev. 2007, 1, 83–136. [Google Scholar] [CrossRef]
- Prior, R.L.; Lazarus, S.A.; Cao, G.; Muccitelli, H.; Hammerstone, J.F. Identification of procyanidins and anthocyanins in blueberries and cranberries (Vaccinium spp.) using high-performance liquid chromatography/mass spectrometry. J. Agric. Food Chem. 2001, 49, 1270–1276. [Google Scholar] [CrossRef] [PubMed]
- White, B.L.; Howard, L.R.; Prior, R.L. Impact of different stages of juice processing on the anthocyanin, flavonol, and procyanidin contents of cranberries. J. Agric. Food Chem. 2011, 59, 4692–4698. [Google Scholar] [CrossRef]
- Liska, D.J.; Kern, H.J.; Maki, K.C. Cranberries and Urinary Tract Infections: How Can the Same Evidence Lead to Conflicting Advice? Available online: https://www.ncbi.nlm.nih.gov/pmc/articles/PMC4863270/ (accessed on 8 September 2020).
- Desbois, A.P.; Smith, V.J. Antibacterial free fatty acids: Activities, mechanisms of action and biotechnological potential. Appl. Microbiol. Biotechnol. 2010, 85, 1629–1642. [Google Scholar] [CrossRef]
- Xu, X.; Xie, B.; Pan, S.; Liu, L.; Wang, Y.; Chen, C. Effects of sea buckthorn procyanidins on healing of acetic acid-induced lesions in the rat stomach. Asia Pac. J. Clin. Nutr. 2007, 16 (Suppl. 1), 234–238. [Google Scholar]
- Eccleston, C.; Baoru, Y.; Tahvonen, R.; Kallio, H.; Rimbach, G.H.; Minihane, A.M. Effects of an antioxidant-rich juice (sea buckthorn) on risk factors for coronary heart disease in humans. J. Nutr. Biochem. 2002, 13, 346–354. [Google Scholar] [CrossRef]
- Yang, B.; Kalimo, K.O.; Tahvonen, R.L.; Mattila, L.M.; Katajisto, J.K.; Kallio, H.P. Effect of dietary supplementation with sea buckthorn (Hippophaë rhamnoides) seed and pulp oils on the fatty acid composition of skin glycerophospholipids of patients with atopic dermatitis. J. Nutr. Biochem. 2000, 11, 338–340. [Google Scholar] [CrossRef]
- Le Bell, A.M.; Soderling, E.; Rantane, I.; Yang, B.; Kallio, H. Frontiers|The Anticancer Activity of Sea Buckthorn [Elaeagnus rhamnoides (L.) A. Nelson]|Pharmacology. Available online: https://www.frontiersin.org/articles/10.3389/fphar.2018.00232/full (accessed on 8 September 2020).
- Tian, J.; Liu, C.; Xiang, H.; Zheng, X.; Peng, G.; Zhang, X.; Du, G.; Qin, X. Investigation on the antidepressant effect of sea buckthorn seed oil through the GC-MS-based metabolomics approach coupled with multivariate analysis. Food Funct. 2015, 6, 3585–3592. [Google Scholar] [CrossRef]
- Erkkola, B.; Baoru, Y. Sea Buckthorn Oils: Towards Healthy Mucous Membranes|Request PDF. Available online: https://www.researchgate.net/publication/287943514_Sea_buckthorn_oils_Towards_healthy_mucous_membranes (accessed on 8 September 2020).
- Jintao, X.; Yongli, S.; Liming, Y.; Quanwei, Y.; Chunyan, L.; Xingyi, C.; Yun, J. Near-infrared spectroscopy for rapid and simultaneous determination of five main active components in rhubarb of different geographical origins and processing. Spectrochim. Acta Part A Mol. Biomol. Spectrosc. 2018, 205, 419–427. [Google Scholar] [CrossRef]
- Ye, M.; Han, J.; Chen, H.; Zheng, J.; Guo, D. Analysis of phenolic compounds in rhubarbs using liquid chromatography coupled with electrospray ionization mass spectrometry. J. Am. Soc. Mass Spectrom. 2007, 18, 82–91. [Google Scholar] [CrossRef] [PubMed]
- Weaver, C.M.; Heaney, R.P.; Nickel, K.P.; Packard, P.I. Calcium Bioavailability from High Oxalate Vegetables: Chinese Vegetables, Sweet Potatoes and Rhubarb. J. Food Sci. 1997, 62, 524–525. [Google Scholar] [CrossRef]
- Zhou, K.; Yu, L. Total phenolic contents and antioxidant properties of commonly consumed vegetables grown in Colorado. LWT Food Sci. Technol. 2006, 39, 1155–1162. [Google Scholar] [CrossRef]
- Takeoka, G.R.; Dao, L.; Harden, L.; Pantoja, A.; Kuhl, J.C. Antioxidant activity, phenolic and anthocyanin contents of various rhubarb (Rheum spp.) varieties. Int. J. Food Sci. Technol. 2013, 48, 172–178. [Google Scholar] [CrossRef]
- Huang, Q.; Lu, G.; Shen, H.-M.; Chung, M.C.M.; Ong, C.N. Anti-cancer properties of anthraquinones from rhubarb. Med. Res. Rev. 2007, 27, 609–630. [Google Scholar] [CrossRef]
- Bartkiene, E.; Lele, V.; Ruzauskas, M.; Domig, K.J.; Starkute, V.; Zavistanaviciute, P.; Bartkevics, V.; Pugajeva, I.; Klupsaite, D.; Juodeikiene, G.; et al. Lactic Acid Bacteria Isolation from Spontaneous Sourdough and Their Characterization Including Antimicrobial and Antifungal Properties Evaluation. Microorganisms 2019, 8, 64. [Google Scholar] [CrossRef]
- Santoshkumar, J.; Manjunath, S.; Sakhare Pranavkumar, M. A Study of Anti-Hyperlipidemia, Hypolipedimic and Anti-Atherogenic Activity of Fruit of Emblica Officinalis (AMLA) in High Fat Fed Albino Rats-Indian Journals. Available online: http://www.indianjournals.com/ijor.aspx?target=ijor:ijmrhs&volume=1&issue=2&article=012 (accessed on 8 September 2020).
- Goyal, R.K.; Kingsly, A.R.P.; Kumar, P.; Walia, H. Physical and mechanical properties of aonla fruits. J. Food Eng. 2007, 82, 595–599. [Google Scholar] [CrossRef]
- Singh, S.; Singh, A.; Joshi, H.K. Standardization of Maturity Indices in Indian Gooseberry (Emblica Afficitlalis) Under Semi-Arid Conditions of Gujarat. Available online: https://www.semanticscholar.org/paper/Standardization-of-maturity-indices-in-Indian-under-Singh-Singh/ed985ea2343fdc6ac6df8fe6628d256393312a9c (accessed on 8 September 2020).
- Murthy, Z.V.P.; Joshi, D. Fluidized Bed Drying of Aonla (Emblica officinalis). Dry. Technol. 2007, 25, 883–889. [Google Scholar] [CrossRef]
- Denev, P.; Číž, M.; Kratchanova, M.; Blazheva, D. Black chokeberry (Aronia melanocarpa) polyphenols reveal different antioxidant, antimicrobial and neutrophil-modulating activities. Food Chem. 2019, 284, 108–117. [Google Scholar] [CrossRef]
- Scalbert, A. Antimicrobial properties of tannins. Phytochemistry 1991, 30, 3875–3883. [Google Scholar] [CrossRef]
- Taguri, T.; Tanaka, T.; Kouno, I. Antimicrobial Activity of 10 Different Plant Polyphenols against Bacteria Causing Food-Borne Disease. Available online: https://www.jstage.jst.go.jp/article/bpb/27/12/27_12_1965/_article (accessed on 8 September 2020).
- Toivanen, M.; Huttunen, S.; Duricová, J.; Soininen, P.; Laatikainen, R.; Loimaranta, V.; Haataja, S.; Finne, J.; Lapinjoki, S.; Tikkanen-Kaukanen, C. Screening of binding activity of Streptococcus pneumoniae, Streptococcus agalactiae and Streptococcus suis to berries and juices. Phytother Res. 2010, 24 (Suppl. 1), S95–S101. [Google Scholar] [CrossRef]
- Toivanen, M.; Ryynänen, A.; Huttunen, S.; Duricová, J.; Riihinen, K.; Törrönen, R.; Lapinjoki, S.; Tikkanen-Kaukanen, C. Binding of Neisseria meningitidis pili to berry polyphenolic fractions. J. Agric. Food Chem. 2009, 57, 3120–3127. [Google Scholar] [CrossRef] [PubMed]
- Lian, P.Y.; Maseko, T.; Rhee, M.; Ng, K. The antimicrobial effects of cranberry against Staphylococcus aureus. Food Sci. Technol. Int. 2012, 18, 179–186. [Google Scholar] [CrossRef] [PubMed]
- Lacombe, A.; McGivney, C.; Tadepalli, S.; Sun, X.; Wu, V.C.H. The effect of American cranberry (Vaccinium macrocarpon) constituents on the growth inhibition, membrane integrity, and injury of Escherichia coli O157:H7 and Listeria monocytogenes in comparison to Lactobacillus rhamnosus. Food Microbiol. 2013, 34, 352–359. [Google Scholar] [CrossRef] [PubMed]
- Rauha, J.P.; Remes, S.; Heinonen, M.; Hopia, A.; Kähkönen, M.; Kujala, T.; Pihlaja, K.; Vuorela, H.; Vuorela, P. Antimicrobial effects of Finnish plant extracts containing flavonoids and other phenolic compounds. Int. J. Food Microbiol. 2000, 56, 3–12. [Google Scholar] [CrossRef]
- Cesoniene, L.; Jasutiene, I.; Sarkinas, A. Phenolics and anthocyanins in berries of European cranberry and their antimicrobial activity. Medicina 2009, 45, 992–999. [Google Scholar]
- Chaman, S.; Syed, N.; Danish, Z.; Khan, F.Z. Phytochemical Analysis, Antioxidant and Antibacterial Effects of Sea Buckthorn Berries. Available online: https://europepmc.org/article/med/21715268 (accessed on 8 September 2020).
- Agoramoorthy, G.; Chandrasekaran, M.; Venkatesalu, V.; Hsu, M.J. Antibacterial and antifungal activities of fatty acid methyl esters of the blind-your-eye mangrove from India. Braz. J. Microbiol. 2007, 38, 739–742. [Google Scholar] [CrossRef]
- Wani, T.A.; Wani, S.M.; Ahmad, M.; Ahmad, M.; Gani, A.; Masoodi, F.A. Bioactive profile, health benefits and safety evaluation of sea buckthorn (Hippophae rhamnoides L.): A review. Cogent Food Agric. 2016, 2, 1128519. [Google Scholar] [CrossRef]
- Lu, C.; Wang, H.; Lv, W.; Xu, P.; Zhu, J.; Xie, J.; Liu, B.; Lou, Z. Antibacterial properties of anthraquinones extracted from rhubarb against Aeromonas hydrophila. Fish. Sci. 2011, 77, 375. [Google Scholar] [CrossRef]
- Heinonen, M. Antioxidant activity and antimicrobial effect of berry phenolics—A Finnish perspective. Mol. Nutr. Food Res. 2007, 51, 684–691. [Google Scholar] [CrossRef] [PubMed]
- Skrovankova, S.; Sumczynski, D.; Mlcek, J.; Jurikova, T.; Sochor, J. Bioactive Compounds and Antioxidant Activity in Different Types of Berries. Int. J. Mol. Sci. 2015, 16, 24673–24706. [Google Scholar] [CrossRef] [PubMed]
- Celli, G.B.; Ghanem, A.; Brooks, M.S.-L. A theoretical physiologically based pharmacokinetic approach for modeling the fate of anthocyanins in vivo. Crit. Rev. Food Sci. Nutr. 2017, 57, 3197–3207. [Google Scholar] [CrossRef] [PubMed]
- He, Z.-H.; He, M.-F.; Ma, S.-C.; But, P.P.-H. Anti-angiogenic effects of rhubarb and its anthraquinone derivatives. J. Ethnopharmacol. 2009, 121, 313–317. [Google Scholar] [CrossRef] [PubMed]
- Stephan, D.; Schmitt, A.; Carvalho, S.M.; Seddon, B.; Koch, E. Evaluation of biocontrol preparations and plant extracts for the control of Phytophthora infestans on potato leaves. Eur. J. Plant Pathol. 2005, 112, 235–246. [Google Scholar] [CrossRef]
- Püssa, T.; Raudsepp, P.; Kuzina, K.; Raal, A. Polyphenolic composition of roots and petioles of Rheum rhaponticum L. Phytochem. Anal. 2009, 20, 98–103. [Google Scholar] [CrossRef]
- Kosikowska, U.; Smolarz, H.D.; Malm, A. Antimicrobial activity and total content of polyphenols of Rheum L. species growing in Poland. Cent. Eur. J. Biol. 2010, 5, 814–820. [Google Scholar] [CrossRef]
- Raudsepp, P.; Anton, D.; Roasto, M.; Meremäe, K.; Pedastsaar, P.; Mäesaar, M.; Raal, A.; Laikoja, K.; Püssa, T. The antioxidative and antimicrobial properties of the blue honeysuckle (Lonicera caerulea L.), Siberian rhubarb (Rheum rhaponticum L.) and some other plants, compared to ascorbic acid and sodium nitrite. Food Control 2013, 31, 129–135. [Google Scholar] [CrossRef]
- Hasper, I.; Ventskovskiy, B.M.; Rettenberger, R.; Heger, P.W.; Riley, D.S.; Kaszkin-Bettag, M. Long-term efficacy and safety of the special extract ERr 731 of Rheum rhaponticum in perimenopausal women with menopausal symptoms. Menopause 2009, 16, 117–131. [Google Scholar] [CrossRef]
- Raudsepp, P.; Koskar, J.; Anton, D.; Meremäe, K.; Kapp, K.; Laurson, P.; Bleive, U.; Kaldmäe, H.; Roasto, M.; Püssa, T. Antibacterial and antioxidative properties of different parts of garden rhubarb, blackcurrant, chokeberry and blue honeysuckle. J. Sci. Food Agric. 2019, 99, 2311–2320. [Google Scholar] [CrossRef]


| Inhibition Zones, mm | |||||||||||||||
|---|---|---|---|---|---|---|---|---|---|---|---|---|---|---|---|
| Pathogenic and Opportunistic Bacteria Strains | |||||||||||||||
| B/V and LAB | Klebsiella pneumoniae | Salmonella enterica 24 SPn06 | Pseudomonas aeruginosa 17-331 | Acinetobacter baumannii 17-380 | Proteus mirabilis | MRSA M87fox | Enterococcus faecalis 86 | Enterococcus faecium 103 | Bacillus cereus 18 01 | Streptococcus mutans | Enterobacter cloacae | Citrobacter freundii | Streptococcus epidermis | Staphylococcus haemolyticus | Pasteurella multocida |
| Goo | nd | 12.3 ± 0.2 b | 14.2 ± 0.6 a | 12.1 ± 0.3 c | 13.3 ± 0.7 a | 13.9 ± 0.2 b | nd | nd | nd | 23.0 ± 0.4 a | nd | nd | 19.3 ± 0.2 b | 15.2 ± 0.3 b | 25.6 ± 0.4 c |
| Goo 135 | nd | 11.1 ± 0.3 a | 14.2 ± 0.4 a | 11.3 ± 0.4 b | 13.4 ± 0.1 a | 14.2 ± 0.4 b | 11.6 ± 0.6 a | nd | nd | 23.2 ± 0.6 a | 12.6 ± 0.6 b | 12.3 ± 0.4 a | 14.4 ± 0.3 a | 15.3 ± 0.6 b | 23.4 ± 0.5 b |
| Goo 122 | nd | 13.2 ± 0.1 c | 14.4 ± 0.4 a | 9.1 ± 0.2 a | 12.3 ± 0.4 a | 12.3 ± 0.8 a | nd | 12.6 ± 0.3 | 11.3 ± 0.6 | 24.0 ± 0.3 a | 12.4 ± 0.4 b | 11.1 ± 0.3 a | 17.5 ± 0.2 b | 15.0 ± 0.4 b | 24.6 ± 0.3 b |
| Goo 206 | nd | 11.1 ± 0.6 a | 14.9 ± 0.7 a | 9.2 ± 0.3 a | 11.6 ± 0.3 a | 14.3 ± 0.6 b | 15.6 ± 0.4 b | nd | nd | 24.3 ± 0.7 a | 10.0 ± 0.6 a | 11.6 ± 0.4 a | 18.0 ± 0.6 b | 13.3 ± 0.6 a | 21.2 ± 0.3 a |
| Images of the Inhibition Zones | |||||||||||||||
![]() | ![]() | ![]() | |||||||||||||
| Salmonella enterica 24 SPn06 | ·Pseudomonas aeruginosa 17-331 | Acinetobacter baumanni 17-380 | |||||||||||||
![]() | ![]() | ![]() | |||||||||||||
| Proteus mirabilis | MRSA M87fox | Enterobacter cloacae | |||||||||||||
![]() | ![]() | ![]() | |||||||||||||
| Citrobacter freundii | Staphylococcus epidermidis | Staphylococcus haemolyticus | |||||||||||||
| B/V and LAB | Inhibition Zones, mm | ||||||||||||||||
|---|---|---|---|---|---|---|---|---|---|---|---|---|---|---|---|---|---|
| Pathogenic and Opportunistic Bacteria Strains | |||||||||||||||||
| Enterococcus faecium 103 | Enterococcus faecium 103 | Enterococcus faecium 103 | Enterococcus faecium 103 | Enterococcus faecium 103 | Enterococcus faecium 103 | Enterococcus faecium 103 | Enterococcus faecium 103 | Enterococcus faecium 103 | Enterococcus faecium 103 | Enterococcus faecium 103 | Enterococcus faecium 103 | Enterococcus faecium 103 | Enterococcus faecium 103 | Enterococcus faecalis 86 | Enterococcus faecium 103 | Bacillus cereus 18 01 | |
| Cho | nd | nd | nd | nd | nd | nd | nd | nd | 10.6 ± 0.4 a | 11.4 ± 0.4 a | nd | nd | nd | nd | 20.3 ± 0.6 b | ||
| Cho 135 | nd | nd | nd | nd | nd | nd | nd | nd | 11.3 ± 0.9 a | 14.6 ± 0.9 b | nd | nd | 11.3 ± 0.3 a | 10.2 ± 0.5 a | 20.4 ± 0.5 b | ||
| Cho 122 | nd | nd | nd | nd | nd | nd | nd | nd | 10.4 ± 0.2 a | 16.3 ± 0.4 c | nd | nd | nd | 12.3 ± 0.4 b | 18.8 ± 0.4 a | ||
| Cho 206 | nd | nd | nd | nd | nd | nd | nd | nd | 11.3 ± 0.3 a | 20.9 ± 0.7 d | nd | nd | 14.2 ± 0.2 b | 12.4 ± 0.7 b | 20.0 ± 0.6 b | ||
| Images of the Inhibition Zones | |||||||||||||||||
![]() | ![]() | ||||||||||||||||
| Bacillus cereus | Streptococcus mutans | ||||||||||||||||
![]() | ![]() | ||||||||||||||||
| Staphylococcus haemolyticus | Pasteurella multocida | ||||||||||||||||
| B/V and LAB | Inhibition Zones, mm | ||||||||||||||
|---|---|---|---|---|---|---|---|---|---|---|---|---|---|---|---|
| Pathogenic and Opportunistic Bacteria Strains | |||||||||||||||
| Klebsiella pneumoniae | Salmonella enterica 24 SPn06 | Pseudomonas aeruginosa 17-331 | Acinetobacter baumannii 17-380 | Proteus mirabilis | MRSA M87fox | Enterococcus faecalis 86 | Enterococcus faecium 103 | Bacillus cereus 18 01 | Streptococcus mutans | Enterobacter cloacae | Citrobacter freundii | Streptococcus epidermis | Staphylococcus haemolyticus | Pasteurella multocida | |
| Cra | nd | nd | 17.8 ± 0.7 c | 10.6 ± 0.3 a | nd | 15.0 ± 0.6 c | nd | nd | 17.2 ± 0.4 b | 25.6 ± 0.7 b | 11.7 ± 0.7 a | 11.2 ± 0.3 a | 19.9 ± 0.8 b | 16.6 ± 0.9 a | 26.3 ± 0.5 a |
| Cra 135 | nd | nd | 17.9 ± 0.8 c | 9.2 ± 0.2 a | nd | 14.6 ± 0.5 b | nd | nd | 16.6 ± 0.9 b | 21.3 ± 0.3 a | 12.0 ± 0.4 a | 11.9 ± 0.7 a | 16.8 ± 0.4 a | 19.3 ± 0.4 b | 27.4 ± 0.6 a |
| Cra 122 | nd | nd | 12.2 ± 0.4 a | 11.3 ± 0.1 b | nd | 15.3 ± 0.3 c | nd | nd | 14.4 ± 0.8 a | 25.5 ± 0.4 b | 12.3 ± 0.3 a | 11.0 ± 0.9 a | 15.0 ± 0.9 a | 17.1 ± 0.5 a | 26.6 ± 0.4 a |
| Cho 206 | nd | nd | 15.1 ± 0.3 b | 12.0 ± 0.4 b | nd | 12.2 ± 0.4 a | nd | nd | 14.5 ± 0.4 a | 20.6 ± 0.7 a | 11.1 ± 0.9 a | 11.4 ± 0.4 a | 15.3 ± 0.4 a | 16.2 ± 0.6 a | 26.9 ± 0.3 a |
| Images of the Inhibition Zones | |||||||||||||||
![]() | ![]() | ![]() | |||||||||||||
| Pseudomonas aeruginosa 17-331 | Acinetobacter baumanni 17-380 | MRSA M87fox | |||||||||||||
![]() | ![]() | ![]() | |||||||||||||
| Bacillus cereus 18 01 | Enterobacter cloacae | Citrobacter freundii | |||||||||||||
![]() | ![]() | ![]() | |||||||||||||
| Staphylococcus epidermidis | Staphylococcus haemolyticus | Pasteurella multocida | |||||||||||||
| B/V and LAB | Inhibition Zones, mm | ||||||||||||||
|---|---|---|---|---|---|---|---|---|---|---|---|---|---|---|---|
| Pathogenic and Opportunistic Bacteria Strains | |||||||||||||||
| Klebsiella pneumoniae | Salmonella enterica 24 SPn06 | Pseudomonas aeruginosa 17-331 | Acinetobacter baumannii 17-380 | Proteus mirabilis | MRSA M87fox | Enterococcus faecalis 86 | Enterococcus faecium 103 | Bacillus cereus 18 01 | Streptococcus mutans | Enterobacter cloacae | Citrobacter freundii | Streptococcus epidermis | Staphylococcus haemolyticus | Pasteurella multocida | |
| SeB | nd | nd | 12.0 ± 0.6 a | 12.0 ± 0.4 a | 15.9 ± 0.2 a | 15.6 ± 0.4 a | 11.3 ± 0.9 a | nd | 18.3 ± 0.4 b | 22.8 ± 0.6 a | 12.0 ± 0.6 b | 10.4 ± 0.4 b | 20.3 ± 0.4 b | 17.6 ± 0.3 a | 25.2 ± 0.3 a |
| SeB 135 | nd | nd | 12.3 ± 0.7 a | 11.0 ± 0.7 a | 17.8 ± 0.3 b | 15.3 ± 0.7 a | 17.2 ± 0.7 b | nd | 15.5 ± 0.6 a | 23.7 ± 0.4 a | 10.2 ± 0.2 a | 9.5 ± 0.3 a | 16.3 ± 0.3 a | 18.4 ± 0.5 b | 26.6 ± 0.3 b |
| SeB 122 | nd | 13.1 ± 0.4 | 13.3 ± 0.9 a | 12.1 ± 0.6 a | 17.9 ± 0.4 b | 15.4 ± 0.8 a | 17.1 ± 0.3 b | nd | 18.9 ± 0.3 b | 23.5 ± 0.5 a | 9.6 ± 0.4 a | 11.6 ± 0.6 c | 16.6 ± 0.4 a | 18.8 ± 0.6 b | 26.1 ± 0.2 b |
| SeB 206 | nd | nd | 12.2 ± 0.3 a | 15.5 ± 0.3 b | 16.2 ± 0.6 a | 14.3 ± 0.9 a | 16.3 ± 0.5 b | nd | 16.4 ± 0.2 a | 23.6 ± 0.4 a | 10.3 ± 0.4 a | 10.3 ± 0.4 b | 17.7 ± 0.4 a | 17.0 ± 0.4 a | 26.0 ± 0.4 b |
| Images of the Inhibition Zones | |||||||||||||||
![]() | ![]() | ![]() | |||||||||||||
| Pseudomonas aeruginosa 17-331 | Acinetobacter baumanni 17-380 | Proteus mirabilis | |||||||||||||
![]() | ![]() | ![]() | |||||||||||||
| MRSA M87fox | Bacillus cereus 18 01 | Enterobacter cloacae | |||||||||||||
![]() | ![]() | ![]() | |||||||||||||
| Citrobacter freundii | Staphylococcus epidermidis | Staphylococcus haemolyticus | |||||||||||||
| B/V and LAB | Inhibition Zones, mm | ||||||||||||||
|---|---|---|---|---|---|---|---|---|---|---|---|---|---|---|---|
| Pathogenic and Opportunistic Bacteria Strains | |||||||||||||||
| Klebsiella pneumoniae | Salmonella enterica 24 SPn06 | Pseudomonas aeruginosa 17-331 | Acinetobacter baumannii 17-380 | Proteus mirabilis | MRSA M87fox | Enterococcus faecalis 86 | Enterococcus faecium 103 | Bacillus cereus 18 01 | Streptococcus mutans | Enterobacter cloacae | Citrobacter freundii | Streptococcus epidermis | Staphylococcus haemolyticus | Pasteurella multocida | |
| Rhu | nd | nd | 12.0 ± 0.6 a | 12.0 ± 0.4 a | 15.9 ± 0.2 a | 15.6 ± 0.4 a | 11.3 ± 0.9 a | nd | 18.3 ± 0.4 c | 22.8 ± 0.6 a | 12.0 ± 0.6 c | 10.4 ± 0.4 a | 20.3 ± 0.4 c | 17.6 ± 0.3 a | 25.2 ± 0.3 a |
| Rhu 135 | nd | nd | 12.3 ± 0.7 a | 11.0 ± 0.7 a | 17.8 ± 0.3 b | 15.3 ± 0.7 a | 17.2 ± 0.7 b | nd | 15.5 ± 0.6 a | 23.7 ± 0.4 a | 10.2 ± 0.2 b | 9.5 ± 0.3 a | 16.3 ± 0.3 a | 18.4 ± 0.5 b | 26.6 ± 0.3 b |
| Rhu 122 | nd | 13.1 ± 0.4 | 13.3 ± 0.9 a | 12.1 ± 0.6 a | 17.9 ± 0.4 b | 15.4 ± 0.8 a | 17.1 ± 0.3 b | nd | 18.9 ± 0.3 c | 23.5 ± 0.5 a | 9.6 ± 0.4 a | 11.6 ± 0.6 b | 16.6 ± 0.4 a | 18.8 ± 0.6 b | 26.1 ± 0.2 b |
| Rhu 206 | nd | nd | 12.2 ± 0.3 a | 15.5 ± 0.3 b | 16.2 ± 0.6 a | 14.3 ± 0.9 a | 16.3 ± 0.5 b | nd | 16.4 ± 0.2 b | 23.6 ± 0.4 a | 10.3 ± 0.4 a | 10.3 ± 0.4 a | 17.7 ± 0.4 b | 17.0 ± 0.4 a | 26.0 ± 0.4 a |
| Images of the Inhibition Zones | |||||||||||||||
![]() | ![]() | ||||||||||||||
| Streptococcus mutans | Staphylococcus epidermidis | ||||||||||||||
![]() | ![]() | ||||||||||||||
| Staphylococcus haemolyticus | Pasteurella multocida | ||||||||||||||
Publisher’s Note: MDPI stays neutral with regard to jurisdictional claims in published maps and institutional affiliations. |
© 2020 by the authors. Licensee MDPI, Basel, Switzerland. This article is an open access article distributed under the terms and conditions of the Creative Commons Attribution (CC BY) license (http://creativecommons.org/licenses/by/4.0/).
Share and Cite
Zokaityte, E.; Lele, V.; Starkute, V.; Zavistanaviciute, P.; Ruzauskas, M.; Mozuriene, E.; Cepiene, M.; Ceplinskas, V.; Kairaityte, G.; Lingyte, R.; et al. Antimicrobial Potential of Beverages Preparation Based on Fermented Milk Permeate and Berries/Vegetables. Beverages 2020, 6, 65. https://doi.org/10.3390/beverages6040065
Zokaityte E, Lele V, Starkute V, Zavistanaviciute P, Ruzauskas M, Mozuriene E, Cepiene M, Ceplinskas V, Kairaityte G, Lingyte R, et al. Antimicrobial Potential of Beverages Preparation Based on Fermented Milk Permeate and Berries/Vegetables. Beverages. 2020; 6(4):65. https://doi.org/10.3390/beverages6040065
Chicago/Turabian StyleZokaityte, Egle, Vita Lele, Vytaute Starkute, Paulina Zavistanaviciute, Modestas Ruzauskas, Erika Mozuriene, Marina Cepiene, Vidas Ceplinskas, Gintare Kairaityte, Rasa Lingyte, and et al. 2020. "Antimicrobial Potential of Beverages Preparation Based on Fermented Milk Permeate and Berries/Vegetables" Beverages 6, no. 4: 65. https://doi.org/10.3390/beverages6040065
APA StyleZokaityte, E., Lele, V., Starkute, V., Zavistanaviciute, P., Ruzauskas, M., Mozuriene, E., Cepiene, M., Ceplinskas, V., Kairaityte, G., Lingyte, R., Marciulionis, L., Monstaviciute, E., Pikunaite, M., Smigelskyte, M., Vyzaite, E., Zilinskaite, L., Ruibys, R., & Bartkiene, E. (2020). Antimicrobial Potential of Beverages Preparation Based on Fermented Milk Permeate and Berries/Vegetables. Beverages, 6(4), 65. https://doi.org/10.3390/beverages6040065